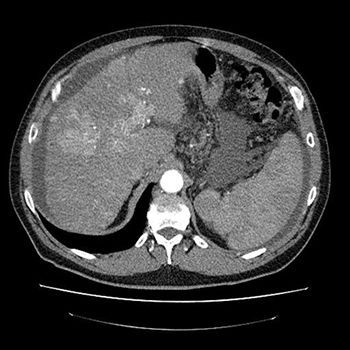
КТ селезёнки в клинике ЦЭЛТ в Москве

КТ селезёнки
КТ селезёнки — инструментальный диагностический метод исследования, направленный на визуализацию органа с целью его изучения и выявления патологий. Он сочетает в себе рентгеновское сканирование с последующей обработкой изображений специализированным ПО. В процессе получается серия послойных снимков с шагом менее одного миллиметра.
Компьютерную томографию селезёнки, как правило, проводят в рамках комплексного исследования внутренних органов брюшины. Изолированно её назначают крайне редко — если имеются показания. Процедура требует применения контрастных веществ, которые позволяют выделить селезёнку среди других органов. Также они дают возможность выявить заболевания сосудов и опухоли добро- или злокачественной природы.
Преимущества КТ селезёнки с контрастированием в ЦЭЛТ
Многие из пациентов, которым надо пройти процедуру контрастной томографии в Москве, выбирают для этого нашу клинику. У нас работают специалисты с более чем 15-летним опытом, которые в совершенстве изучили методику процедуру и способны выявить патологические состояния на ранних стадиях их развития. Они плодотворно сотрудничают с врачами других специальностей благодаря тому, что в нашей клинике имеется ряд служб разного профиля.
Компьютерная томография проводится на современном мультиспиральном шестидесятичетырёхсрезовом томографе производства «General Electric» (США). Она осуществляется в соответствии с международными стандартами и позволяет получить всю необходимую информацию.
Для её прохождения нужно иметь с собой направление от лечащего врача с указанием предварительного диагноза. Такой подход позволяет повысить качество исследования, поскольку диагност будет знать, на что именно нужно обратить особое внимание.
Узнать цену КТ селезёнки можно в соответствующем разделе нашего сайта или позвонив нам: +7 (495) 788-33-88! Мы регулярно обновляем наш прайс-лист, однако во избежание недоразумений всё же рекомендуем звонить нам.
Показания для проведения компьютерной томографии селезёнки
КТ селезёнки позволяет выявить образования любой этиологии наряду с другими заболеваниями органа. Благодаря ей врач имеет возможность оценить состояние его структур и определить наличие патологий на ранних стадиях развития. Это особенно важно, поскольку чем раньше было обнаружено заболевание — тем успешнее будет его лечение.
Процедуру назначают если пациент жалуется на клинические проявления в виде болевых ощущений, локализующихся с левой стороны, или после недавно перенесённых травм. Если в процессе осмотра врач выявил отёчность селезёнки или её патологическое увеличение, у него возникли подозрения на развитие воспалительного процесса — это тоже причины для назначения КТ. Исследование требуется и в том случае, если другие виды диагностики выявили проблему, но не смогли точно её идентифицировать. Томографию проводят при подозрении на:
- патологию, характеризующуюся некрозом селезёнки — её инфаркт;
- такое образование в эпителиальных клетках органа, как киста;
- аномальное увеличение органа — спленомегалия;
- ротация селезёнки вокруг ножки, сопровождающаяся нарушением её кровоснабжения — заворот;
- новообразования добро- или злокачественной природы.
Также КТ позволяет определить такое заболевание, как гемангиома селезёнки, развивающееся во внутриутробном периоде. Иногда диагностика необходима после травматических повреждений грудины или брюшной полости. Она позволяет определить разрывы селезёнки, формирование гематомы с последующим кровотечением в брюшную полость.
Противопоказания для проведения КТ селезёнки
| Противопоказания к обзорной КТ | Противопоказания к КТ с контрастом |
|---|---|
|
|
Как проводят КТ селезёнки?
Исследование проводится натощак. Это значит, что за 4‒6 часов до него не следует принимать пищу. В случае, если применяют контрастные вещества, то врач даёт пациенту рекомендацию исключить на несколько дней потребление пищи, способствующей газообразованию и задержке стула.
Перед процедурой пациента просят снять с себя любые металлические украшения. Сам он должен предоставить направление от своего врача с предварительным диагнозом и областями исследования. Компьютерная томография будет проводиться в соответствии с этим документом, так она сможет определить имеющуюся проблему и поможет врачу точно поставить диагноз.
В случае, если у пациента имеются данные ранее проведённых исследований, их тоже нужно предоставить. Они помогут составить целостную клиническую картину. Такой, комплексный подход позволяет добиться максимальной информативности исследования.
Перед началом процедуры пациента попросят прилечь на стол томографа и зафиксируют его голову. Он сдвинется непосредственно в томограф, и начнётся сканирование. Во время его проведения пациенту нужно лежать неподвижно, не обращая внимания на шум и щелки, которые издаёт оборудование.
Если в процессе проведения процедуры у пациента возникают неприятные ощущения, он может обратиться к специалисту, который её проводит, воспользовавшись громкой связью.
Введение контраста позволяет получить более качественное изображение. Его вводят перед сканированием двумя способами: посредством внутривенной инъекции или орально (пациент выпивает препарат). Выведение из организма после процедуры требует питья большого количества жидкости.
Расшифровка результатов КТ селезёнки
Данный вид диагностического исследования очень информативен. На КТ можно определить размеры селезёнки и их соответствие норме, выявить аномалии функционирования и развития, определить состояние стенок кровеносных сосудов, выявить патологические состояния на любых стадиях развития.
Отзывы пациентов
Все отзывыУслуги по направлению Компьютерная томография
-
-
Внутривенное введение контрастного препарата (дополнительно к основному исследованию)
7.400 ₽ -
Выдача данных компьютерно-томаграфического исследования на рентгеновской пленке (1 лист) (с НДС)
700 ₽ -
Выдача дубликата компьютерно-томографического исследования на диске (с НДС)
700 ₽ -
Компьютерная кавернозография с контрастированием
30.000 ₽ -
Компьютерная томография верхней конечности
9.500 ₽ -
Компьютерная томография верхней конечности с внутривенным болюсным контрастированием
15.800 ₽ -
Компьютерная томография гипофиза
7.400 ₽ -
Компьютерная томография гипофиза с внутривенным контрастированием
14.700 ₽ -
Компьютерная томография голеностопного сустава
9.500 ₽ -
Компьютерная томография головного мозга
7.400 ₽ -
Компьютерная томография грудного отдела аорты и брахиоцефальных артерий
18.900 ₽ -
Компьютерная томография коленного сустава
8.400 ₽ -
Компьютерная томография костей черепа
8.400 ₽ -
Компьютерная томография лицевого отдела черепа с внутривенным болюсным контрастированием, мультипланарной и трехмерной реконструкцией
11.600 ₽ -
Компьютерная томография локтевого сустава
9.500 ₽ -
Компьютерная томография лучезапястного сустава
10.500 ₽ -
Компьютерная томография мочевого пузыря
9.500 ₽ -
Компьютерная томография мягких тканей шеи
10.500 ₽ -
Компьютерная томография надпочечников с внутривенным болюсным контрастированием
12.600 ₽ -
Компьютерная томография нижней конечности
10.500 ₽ -
Компьютерная томография нижней конечности с внутривенным болюсным контрастированием
17.900 ₽ -
Компьютерная томография органов брюшной полости и забрюшинного пространства
9.500 ₽ -
Компьютерная томография органов брюшной полости и забрюшинного пространства с внутривенным контрастированием
16.800 ₽ -
Компьютерная томография органов брюшной полости, забрюшинного пространства и малого таза
12.600 ₽ -
Компьютерная томография органов брюшной полости, забрюшинного пространства и малого таза с внутривенным контрастированием
22.100 ₽ -
Компьютерная томография органов грудной клетки, брюшной полости и забрюшинного пространства
15.800 ₽ -
Компьютерная томография органов грудной клетки, брюшной полости и забрюшинного пространства с внутривенным контрастированием
22.100 ₽ -
Компьютерная томография органов грудной клетки, брюшной полости, забрюшинного пространства и малого таза
18.900 ₽ -
Компьютерная томография органов грудной клетки, брюшной полости, забрюшинного пространства и малого таза с внутривенным контрастированием
26.300 ₽ -
Компьютерная томография органов грудной клетки, низкодозовая
5.800 ₽ -
Компьютерная томография органов грудной полости
7.400 ₽ -
Компьютерная томография органов грудной полости с внутривенным болюсным контрастированием
14.700 ₽ -
Компьютерная томография органов малого таза
8.400 ₽ -
Компьютерная томография органов малого таза с контрастированием
15.800 ₽ -
Компьютерная томография органов мочевыделения с внутривенным контрастированием
15.800 ₽ -
Компьютерная томография плечевого сустава
8.400 ₽ -
Компьютерная томография позвоночника
9.000 ₽ -
Компьютерная томография почек и надпочечников
7.400 ₽ -
Компьютерная томография придаточных пазух носа
6.900 ₽ -
Компьютерная томография сердца
8.000 ₽ -
Компьютерная томография сердца с контрастированием
12.000 ₽ -
10.500 ₽
-
Компьютерная томография тазобедренного сустава
8.400 ₽ -
9.500 ₽
-
Компьютерная томография челюстно-лицевой области (верхней или нижней челюсти)
6.300 ₽ -
Компьютерная томография шеи с внутривенным болюсным контрастированием
17.900 ₽ -
Компьютерная-томография головного мозга с внутривенным контрастированием
14.700 ₽ -
Компьютерно-томографическая ангиография аорты
19.900 ₽ -
Компьютерно-томографическая ангиография брюшной аорты и подвздошных сосудов
17.900 ₽ -
Компьютерно-томографическая ангиография легочных сосудов
17.900 ₽ -
Компьютерно-томографическая ангиография сосудов верхних конечностей
17.850 ₽ -
Компьютерно-томографическая ангиография сосудов нижних конечностей
21.000 ₽ -
Компьютерно-томографическая ангиография сосудов почек
13.700 ₽ -
Компьютерно-томографическая коронарография
19.900 ₽ -
Компьютерно-томографическая оценка коронарного кальция
5.300 ₽ -
Компьютерно-томографическая флебография нижней полой вены (и вен малого таза)
16.800 ₽ -
Компьютерно-томографическая шунтография
12.600 ₽ -
Консультация КТ или МРТ исследования, выполненного не в ЦЭЛТ (возможность консультации оценивает врач-рентгенолог)
4.800 ₽ -
-
14.700 ₽
-
КТ височно-нижнечелюстного сустава
12.600 ₽ -
10.500 ₽
-
-
9.500 ₽
-
8.400 ₽
-
КТ левого предсердия и легочных вен
15.800 ₽ -
8.400 ₽
-
-
8.400 ₽
-
4.200 ₽
-
КТ-скрининг заболеваний легких и сосудов сердца
8.500 ₽ -
Получение данных компьютерно-томографического исследования на флешкарте (с НДС)
1.000 ₽
Почему нам доверяют?
-
Более 30 лет активной работы
Опыт позволяет нам находить решения даже в самых нестандартных случаях.
Запись на прием
Запишитесь к интересующему вас специалисту
Выбрать специалиста